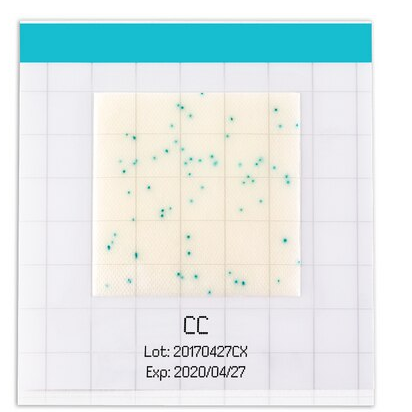
MC-MEDIA PAD COLIFORMES - 100 testes

R$ 715,90
até
6x
de
R$ 119,31
sem juros
Compre agora
Disponibilidade: 3 dias úteis
Aproveite! Restam apenas 10 unidades
-
- 1x de R$ 715,90 sem juros
- 2x de R$ 357,95 sem juros
- 3x de R$ 238,63 sem juros
- 4x de R$ 178,97 sem juros
- 5x de R$ 143,18 sem juros
- 6x de R$ 119,31 sem juros
-
- 1x de R$ 715,90 sem juros
- 2x de R$ 392,46
- 3x de R$ 265,43
-
R$ 715,90

Meio de cultura desidratado para detecção de coliformes.
Armazenar entre +2°C a +8°C.
MC Media Pads são prontos para uso e fornecem o melhor custo benefício do mercado:
Produtos relacionados
Categorias
Conteúdo
- Fale Conosco
- Meios de Cultura para Laboratório: Da Descoberta à Utilização nos Dias Atuais
- PLACA DE PÉTRI: HISTÓRIA E APLICAÇÃO ATUAL.
- Política de privacidade
- Política de Trocas e Devoluções
- Quem somos
- Vidrarias de Laboratório: Conheça as Funções e a Importância dos Frascos Reagentes de Vidro Borossil
Sobre a loja
A Petri Lab é uma loja completa para equipar o seu laboratório com equipamentos e consumíveis de qualidade. Encontre tudo que precisa para pesquisa e análises com preços competitivos e entrega rápida para todo o Brasil.
Pague com
Selos